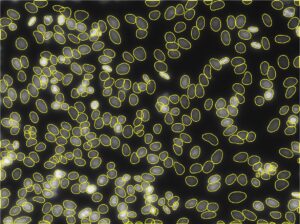

MODULE
AI Deep Learning
Remarkably Accurate. Delightfully Efficient.
Harness next generation Deep Learning technology to unlock image segmentation accuracy that you never thought possible.
Segment anything
with remarkable and dependable accuracy over Machine Learning techniques.
 Deep Learning
Deep Learning
 Machine Learning
Machine Learning
Overcome low contrast
Unhindered by clumping or unclear edges
 Deep Learning
Deep Learning
 Machine Learning
Machine Learning
Handle complex detail
Finds similar objects, not just intensities
 Deep Learning
Deep Learning
 Machine Learning
Machine Learning
Find unique patterns
Handles any shape of object or phase
 Deep Learning
Deep Learning
 Machine Learning
Machine Learning
Handle intricate detail
Unhindered by touching or overlapping objects

Superior outline accuracy
Even the most complicated edges can be traced with high quality. AI Models work similar to the human brain, finding objects undeterred by dim, complex edges.

User-friendly operation
AI Deep Learning Segmentation requires minimal input to operate efficiently. Simple controls, limited options, and fast prediction results.

Secure & confidential
No uploading or downloading required. Save time and avoid sharing your data on unsecure company servers. All operations are on-device.

Protocol-ready
Integrate Deep Learning Segmentation accuracy into an automated workflow by saving an Analysis Protocol with a custom or pre-trained model.
Ready-to-use model library
Benefit from an expanding library of pre-trained models for a wide range of 2D image analysis applications
Don't see your application?
Check out the ever-expanding library of AI-powered solutions
What our customers have to say
The AI Deep Learning segmentation function provides an extremely flexible and efficient tool to segment features for sizing and counting. A variety of pre-trained models provide a solid foundation to build upon and modify to tailor your individual challenges. AI Deep Learning segmentation has greatly improved my efficiency with remarkable performance.
Dale K. Purcell, PhD
President at Chemical Microscopy LLC
Fine-tune any model
When a model misses a few objects of interest, simple "human-in-the-loop" training is needed

Predict
Find objects with an existing model
Fine-tune
Label any missing objects
Train
Train model to detect all objects
Expert-level model training
![]() Key Model training features
Key Model training features
Restore points
Need a redo? No problem.
Restore to a previous training point.
Train from new
Start a model from scratch
and use your own images.
Model lock
Protect Models from being
edited once perfected.
Model import
Load models or labels
from the community.
Object size estimator
Tune in the model settings to
find the right object size faster.
Instance & Semantic
Look for objects or
simply classify pixels.
Made possible with cutting-edge technology
The Image-Pro Neural Engine™ is installed on-device to leverage Convolutional Neural Networks (CNNs) at scale, using a single intuitive user interface for model Prediction, Fine-tuning, and Training.
With a single platform, nearly any Neural Network can be added to bring the latest Deep Learning capabilities to Image-Pro. The current architectures available include: CellPose, StarDist, and BaseUNET.

Resources

Like what you see?
Get Started with AI Deep Learning for Image-Pro